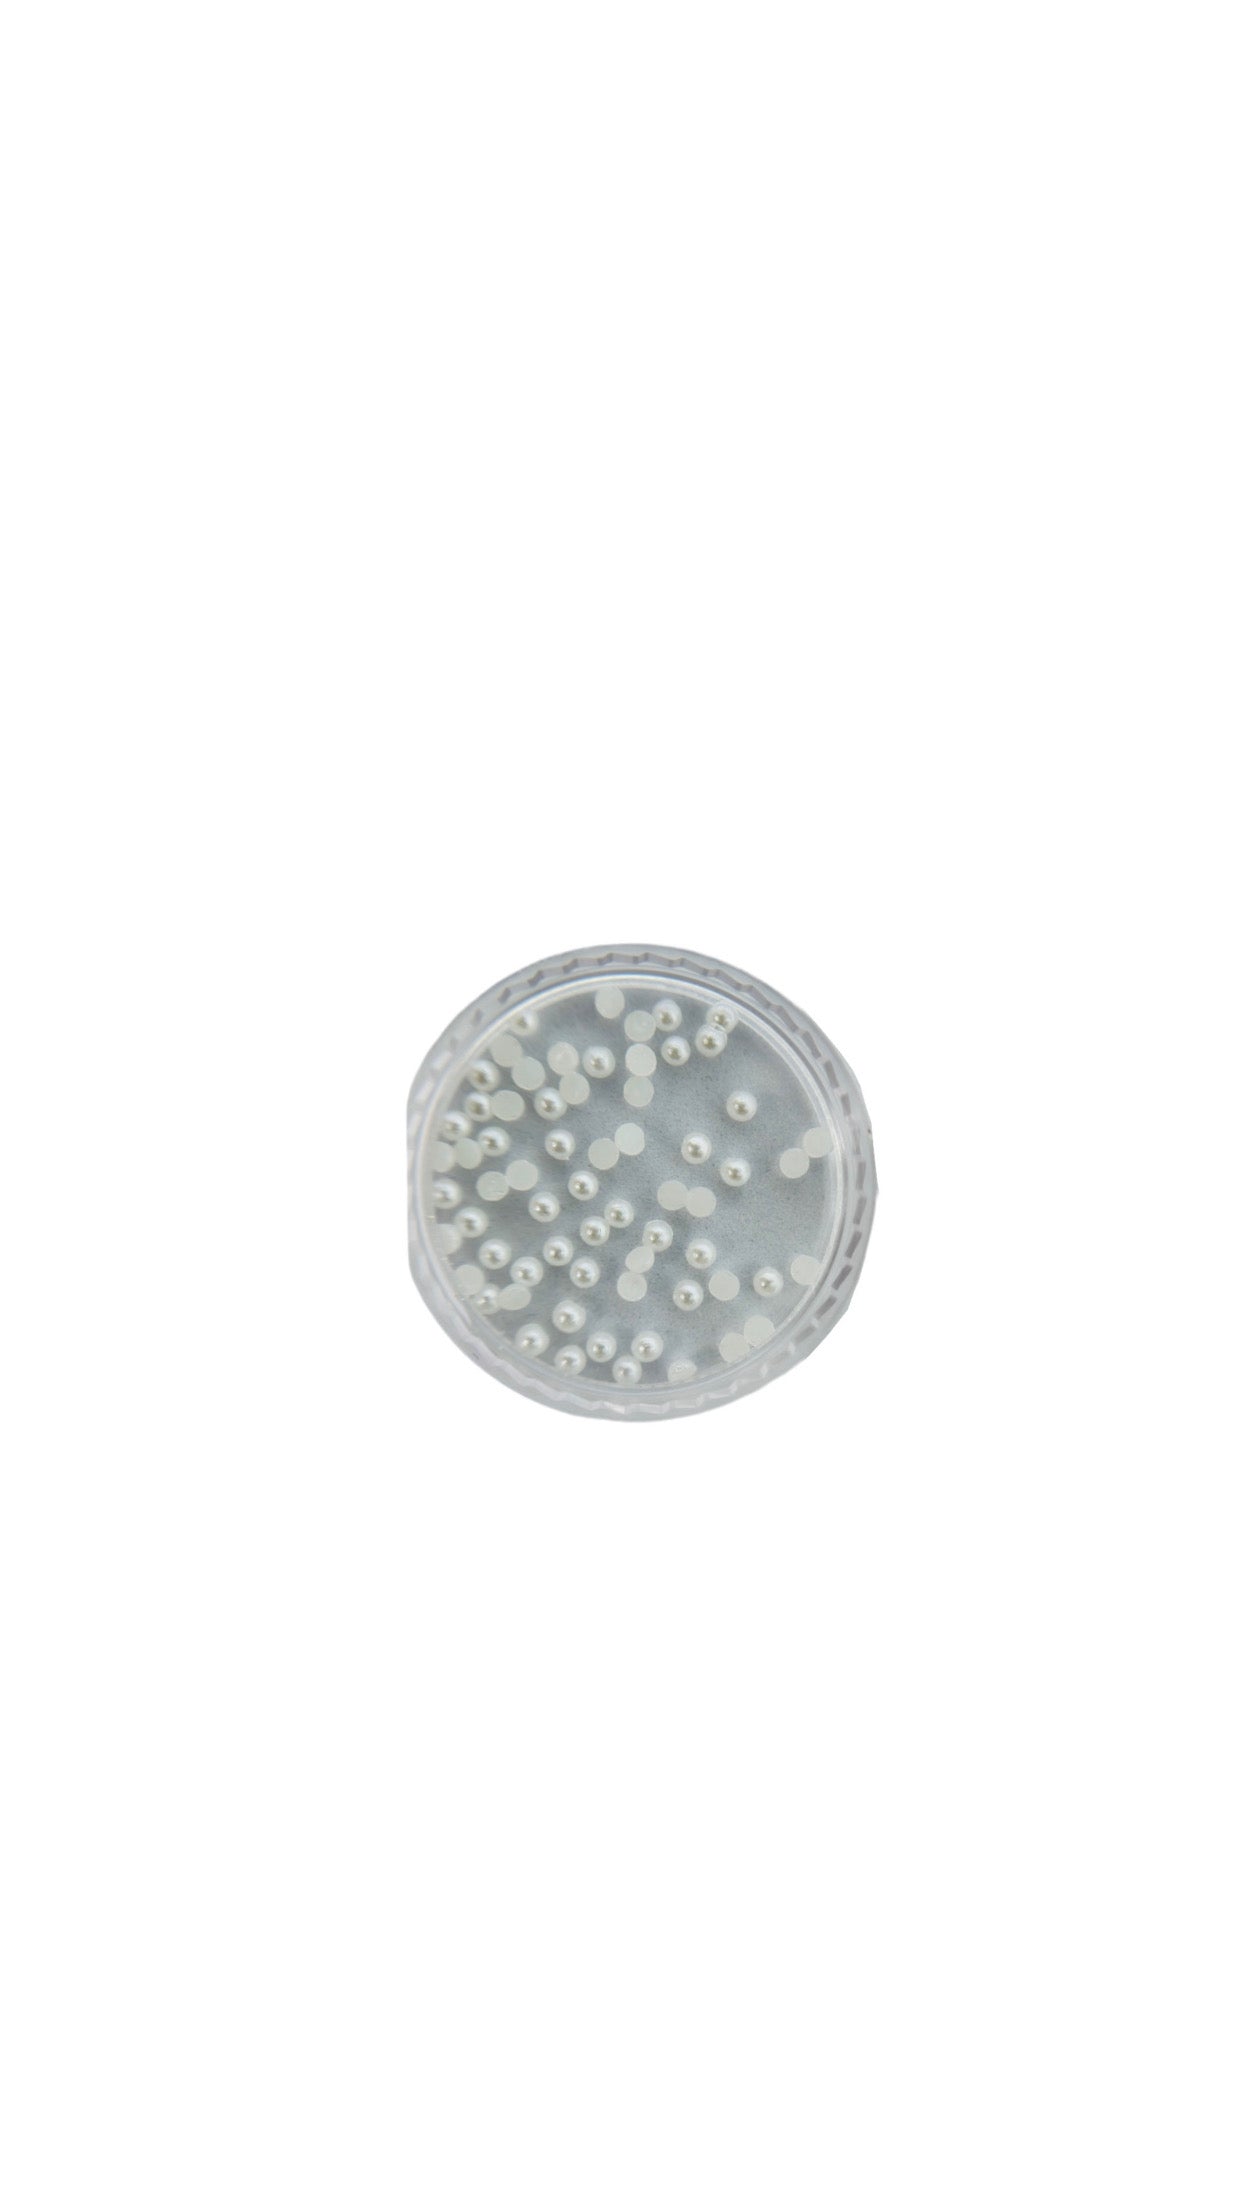

1
/
שֶׁל
1
No reviews
אבני פנינים
אבני פנינים
מחיר רגיל
₪15.00
מחיר רגיל
מחיר מבצע
₪15.00
מחיר ליחידה
/
לְכָל
משלוח מחושב בקופה.
מק"ט:
אבני הפנינים שלנו לציפורניים מעניקות מראה יוקרתי ואלגנטי עם ברק עדין. הן מושלמות להוספת נגיעה של תחכום וייחודיות לכל מניקור, ויוצרות עיצוב קלאסי ומרהיב שמתאים לכל אירוע.
במלאי
לא ניתן היה לטעון את זמינות האיסוף
Share
הקולקציות הבלעדיות שלנו
המשימה שלנו
בקלאסיס המשימה שלנו היא לספק למקצועניות ציפורניים ולחובבות ציפורניים את המוצרים והכלים האיכותיים ביותר, תוך הקפדה על תוצאות יוצאות דופן. אנו מחויבים לחדשנות, מצוינות ושביעות רצון לקוחות, לעזור לך להשיג עיצובי ציפורניים יפים ועמידים לאורך זמן בקלות.